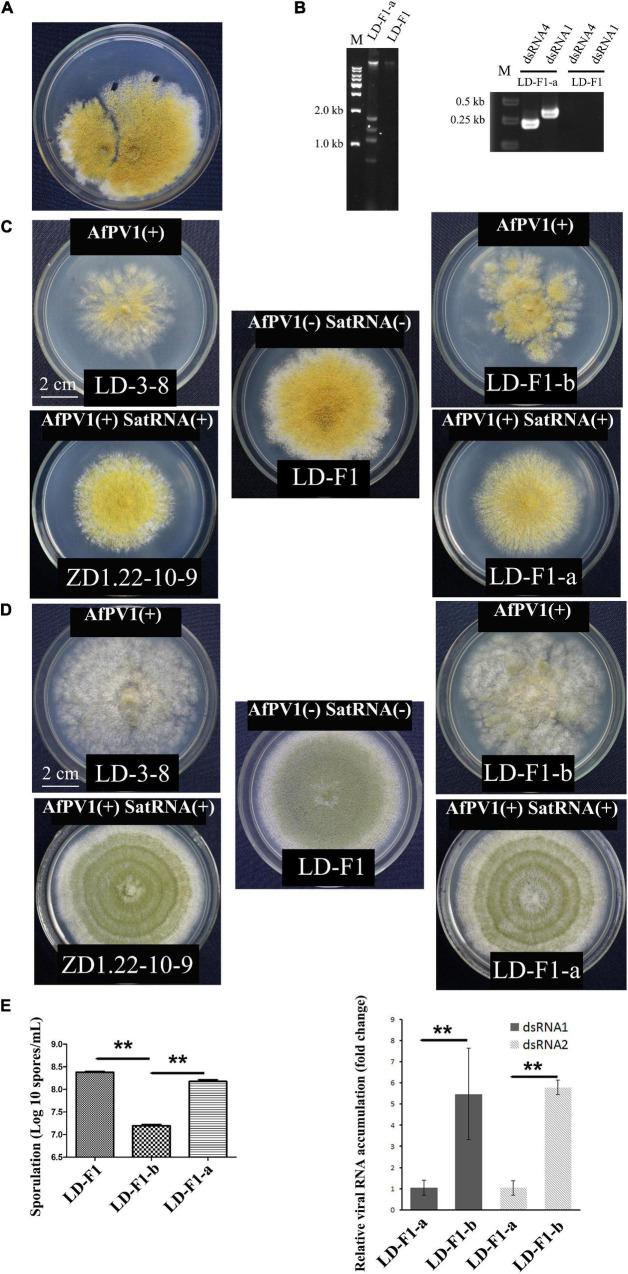
https://cdn.ncbi.nlm.nih.gov/pmc/blobs/b996/9195127/dac1ab451f1a/fmicb-13-895844-g002.jpg

一种卫星双链RNA减轻了辅助病毒介导的症状在……中的诱导。
A Satellite dsRNA Attenuates the Induction of Helper Virus-Mediated Symptoms in .
作者信息
Jiang Yinhui, Yang Bi, Liu Xiang, Tian Xun, Wang Qinrong, Wang Bi, Zhang Qifang, Yu Wenfeng, Qi Xiaolan, Jiang Yanping, Hsiang Tom
机构信息
Key Laboratory of Endemic and Ethnic Diseases, Ministry of Education, Guizhou Medical University, Guiyang, China.
Key Laboratory of Medical Molecular Biology, Guizhou Medical University, Guiyang, China.
出版信息
Front Microbiol. 2022 May 31;13:895844. doi: 10.3389/fmicb.2022.895844. eCollection 2022.
is an important fungal pathogen of animals and plants. Previously, we reported a novel partitivirus, Aspergillus flavus partitivirus 1 (AfPV1), infecting . In this study, we obtained a small double-stranded (ds) RNA segment (734 bp), which is a satellite RNA of the helper virus, AfPV1. The presence of AfPV1 altered the colony morphology, decreased the number of conidiophores, created significantly larger vacuoles, and caused more sensitivity to osmotic, oxidative, and UV stresses in , but the small RNA segment could attenuate the above symptoms caused by the helper virus AfPV1 in . Moreover, AfPV1 infection reduced the pathogenicity of in corn (), honeycomb moth (), mice (), and the adhesion of conidia to host epithelial cells, and increased conidial death by macrophages. However, the small RNA segment could also attenuate the above symptoms caused by the helper virus AfPV1 in , perhaps by reducing the genomic accumulation of the helper virus AfPV1 in . We used this model to investigate transcriptional genes regulated by AfPV1 and the small RNA segment in , and their role in generating different phenotypes. We found that the pathways of the genes regulated by AfPV1 in its host were similar to those of retroviral viruses. Therefore, some pathways may be of benefit to non-retroviral viral integration or endogenization into the genomes of its host. Moreover, some potential antiviral substances were also found in using this system.
是动植物的一种重要真菌病原体。此前,我们报道了一种新型的分节段病毒,黄曲霉分节段病毒1(AfPV1),它感染……。在本研究中,我们获得了一个小的双链(ds)RNA片段(734 bp),它是辅助病毒AfPV1的卫星RNA。AfPV1的存在改变了菌落形态,减少了分生孢子梗的数量,产生了明显更大的液泡,并导致……对渗透压、氧化和紫外线胁迫更敏感,但小RNA片段可以减轻辅助病毒AfPV1在……中引起的上述症状。此外,AfPV1感染降低了……在玉米(……)、蜂窝蛾(……)、小鼠(……)中的致病性以及分生孢子与宿主上皮细胞的粘附,并增加了巨噬细胞导致的分生孢子死亡。然而,小RNA片段也可以减轻辅助病毒AfPV1在……中引起的上述症状,可能是通过减少辅助病毒AfPV1在……中的基因组积累。我们利用这个模型研究了AfPV1和小RNA片段在……中调控的转录基因,以及它们在产生不同表型中的作用。我们发现AfPV1在其宿主中调控的基因途径与逆转录病毒的相似。因此,一些途径可能有利于非逆转录病毒整合或内源性进入其宿主基因组。此外,利用这个系统在……中还发现了一些潜在的抗病毒物质。